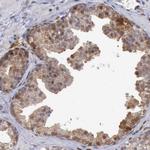
STAT1 Antibody in Immunohistochemistry (Paraffin) (IHC (P))

Search
Invitrogen
STAT1 Polyclonal Antibody
{{$productOrderCtrl.translations['antibody.pdp.commerceCard.promotion.promotions']}}
{{$productOrderCtrl.translations['antibody.pdp.commerceCard.promotion.viewpromo']}}
{{$productOrderCtrl.translations['antibody.pdp.commerceCard.promotion.promocode']}}: {{promo.promoCode}} {{promo.promoTitle}} {{promo.promoDescription}}. {{$productOrderCtrl.translations['antibody.pdp.commerceCard.promotion.learnmore']}}
产品信息
PA5-81907
种属反应
宿主/亚型
分类
类型
抗原
偶联物
形式
浓度
规格
纯化类型
保存液
内含物
保存条件
运输条件
RRID
产品详细信息
Immunogen sequence: FQEDPIQMSM IIYSCLKEER KILENAQRFN QAQSGNIQST VMLDKQKELD SKVRNVKDKV MCIEHEIKSL EDLQDEYDFK CKTLQNREHE TNGVAKSDQK QEQLLLKKMY LMLDNKRKEV VHKIIELLNV TELTQNA
Highest antigen sequence indentity to the following orthologs: Mouse - 86%, Rat - 87%.
靶标信息
STAT1 (signal transducers and activators of transcription 1) is a member of the STAT family of transcription factors. STAT1 can be activated by interferon-alpha, interferon-gamma, EGF, PDGF and IL6. STAT1 is known to regulate several genes which are involved in cell growth, apoptosis, immune responses, and lipid metabolism. Further, STAT1 plays an important role in mediating cell viability in response to different cell stimuli and pathogen exposure. The STAT1 gene is located on chromosome 2. STAT1 is activated to regulate gene expression in response to extracellular signaling polypeptides including cytokines, interferons, and growth factors. After phosphorylation by JAK tyrosine kinases, STAT1 enters the nucleus to regulate transcription of many different genes. Among the seven STATs types, STAT1, STAT3, STAT5a, and STAT5b have a wide activation profile. STAT1 is activated by many different ligands including IFN family (IFN-Alpha, IFN-Beta, IFN-gamma and IL-10), gp130 family (IL-6, IL-11, LIF, CNTF, and G-CSF), and receptor tyrosine kinases (EGF, PDGF, and CSF-1). Two alternatively spliced transcript variants encoding distinct isoforms of STAT1 have been described.
仅用于科研。不用于诊断过程。未经明确授权不得转售。
篇参考文献 (0)
生物信息学
蛋白别名: DKFZp686B04100; OTTHUMP00000165046; OTTHUMP00000205845; signal transducer and activator of transcription 1, 91kD; signal transducer and activator of transcription 1, 91kDa; Signal transducer and activator of transcription 1-alpha/beta; STAT; STAT 1; STAT-1; stat1 alpha; transcription factor; Transcription factor ISGF-3 components p91/p84; transcription factor; 91 kDa; unnamed protein product
基因别名: CANDF7; IMD31A; IMD31B; IMD31C; ISGF-3; STAT1; STAT91
UniProt ID: (Human) P42224
Entrez Gene ID: (Human) 6772